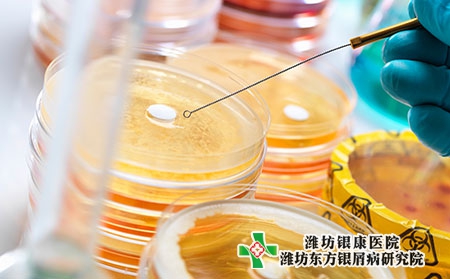
得了牛皮癬治療方法是什么_南京哪個醫院銀屑病靠譜

得了牛皮癬治療方法是什么_南京哪個醫院銀屑病靠譜
南京哪個醫院銀屑病靠譜?牛皮癬是一種非常棘手的疾病,治療也非常棘手,因此許多患者對牛皮癬的治療失去了信心。對于牛皮癬這一疾病,一定要盡早治療,不要拖拉,等病情加重后會更難治療。牛皮癬的治療方法很多,但病人還是要選擇適合自己情況的那一種,否則治療不會有效果。那南京的病人得了牛皮癬治療方法是什么?
牛皮癬是一種頑固性疾病,牛皮癬患者的發病原因很多,因此病人的治療方法很多。但病人不能隨意選擇,只有在了解了病因后,才能更好地選擇適合自己的治療方法。
病人接受正規醫院的專業治療:
病人接受正規醫院的專業治療是保證銀屑病患者盡早得到良好治療的重要因素,制定系統的個體化治療方案,謹遵醫囑服藥,是銀屑病治療的重點。與醫生合作進行治療,使治療效果更佳。
牛皮癬的治療時間較長:
牛皮癬的治療時間較長,一般需要治療很長的時間才能見效。所以,病人應堅持治療,切不可因短期治療效果不佳而隨意更換藥物,甚至暫停治療,以免延誤病情,給病情以可乘之機。牛皮癬患者在治療時,一定要多觀察自己的皮膚癥狀,一旦發現自己的情況有變化,一定要及時和自己的醫生聯系,找出引起這種變化的原因,正確、科學地進行治療,取得良好的治療效果。
南京哪個醫院銀屑病靠譜?牛皮癬的治療方法有很多種,病人在治療牛皮癬的時候還是要選擇適合自己的那一種,只有適合自己的那一種才是對的。有些病人由于對牛皮癬還不夠了解,不知道哪種方法對自己有比較好的治療效果,錯誤的方法治療牛皮癬會對自己的病情產生一定的影響。
東方銀屑病研究院(二級專科醫院)創建于1992年,是由衛生部門批準創辦的一家集銀屑病科研、醫療、康復、保健和預防為一體的專業研究診療機構;致力于打造一家高起點、高技術、高水準的銀屑病專業醫院,為廣大銀屑病患者提供專業、系統的醫療和護理服務。未來我們將扎實基礎,切實的深入預防保健工作,成為德才兼備的銀屑病專業診療基地;成為“就醫一次,服務終生”的全面化醫療機構!
【具體治療方案可咨詢濰坊東方銀屑病研究院,謹遵醫囑,切勿自行用藥。如果您無法確定自身病情,可點擊右側咨詢窗口,或撥打我院電話0536-3087125,提供自己的皮膚病照片,我們會為您識別并提供相關治療建議。】









